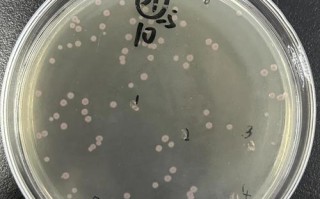
新生儿人亚种葡萄球菌

看到宝宝脸上长了湿疹,爸爸妈妈肯定非常心疼和着急,别担心,新生儿湿疹非常常见,通常是可以控制和管理的,下面为您详细梳理一下应对新生儿湿疹的步骤和方法,从日常护理到用药,希望能帮助到您。

(图片来源网络,侵删)
核心原则:保湿、保湿、再保湿!
对于大部分新生儿湿疹,保湿是基础和关键,湿疹宝宝的皮肤屏障功能比较弱,容易干燥,从而引发瘙痒和炎症,做好保湿,能从根本上改善皮肤状况。
第一步:基础日常护理(重中之重)
这是控制湿疹最有效、最安全的方法,需要持之以恒。
温和清洁:
- 水温: 使用温水(约37-38℃,用手腕试感觉不烫为宜),过热的水会加重皮肤干燥。
- 沐浴产品: 使用无皂基、无香料、低敏或专为敏感肌设计的婴儿沐浴露,每周使用1-2次即可,平时用清水冲洗。
- 时间: 沐浴时间不宜过长,5-10分钟为佳。
- 方式: 用柔软的纱布巾或纯棉毛巾轻轻拍洗,避免用力搓揉。
科学保湿(关键步骤):

(图片来源网络,侵删)
- 时机: 在宝宝洗完澡后3分钟内,趁皮肤还微微湿润时立即涂抹保湿霜,这个时机能锁住最多水分,效果最好。
- 频率: 每天至少涂抹3-5次,甚至更多,只要感觉皮肤干了就可以涂,天气干燥或开空调暖气时,更要勤涂。
- 用量: 要足量!不要小气,每次都要厚涂,像“抹奶油”一样。
- 产品选择:
- 首选霜或膏: 相比于乳液,霜和膏的含油量和锁水能力更强,更适合湿疹宝宝,推荐选择无香料、无色素、无酒精、无致敏防腐剂的医用级保湿霜(也叫“医用保湿剂”或“医用润肤剂”),如丝塔芙大白罐、CeraVe、Aveeno Baby燕麦霜、优色林、理肤泉B5等。
- 避免: 避免使用成人护肤品、含有过多香精、酒精或复杂成分的产品。
避免刺激和过敏原:
- 衣物: 给宝宝穿纯棉、宽松、柔软的衣物,避免羊毛、化纤等直接接触皮肤,新衣服一定要洗过再穿。
- 环境:
- 保持室内温度凉爽,湿度适宜(50%-60%),避免过热和出汗,汗液会刺激湿疹。
- 勤换床单、被套,避免尘螨。
- 避免宝宝接触宠物毛发、二手烟、香水、空气清新剂等。
- 洗涤剂: 使用婴儿专用的、无香料的洗衣液,并确保彻底漂洗干净,可以额外增加一次漂洗程序。
防止抓挠:
- 勤剪指甲: 随时保持宝宝的指甲短而光滑。
- 睡觉时戴手套: 如果宝宝在夜间抓挠严重,可以考虑给宝宝戴上透气的小手套或长连体衣。
- 转移注意力: 当宝宝想抓挠时,用玩具或游戏吸引他的注意力。
- 冷敷: 瘙痒难忍时,可以用干净的纱布包裹冰袋(或冷藏过的医用保湿罐),在湿疹部位进行短暂冷敷,可以快速缓解痒感。
第二步:根据严重程度,考虑使用药物
如果通过以上精心护理,湿疹仍然没有好转,或者出现以下情况,请及时咨询医生:
- 皮肤红肿、增厚、粗糙非常明显。
- 宝宝因为剧烈瘙痒而哭闹不止,影响睡眠和进食。
- 皮肤出现渗水、流黄水、结黄痂,可能是继发了细菌感染。
外用激素药膏(在医生指导下使用):

(图片来源网络,侵删)
- 不要“谈激素色变”:对于中重度湿疹,外用激素药膏是一线治疗药物,能有效快速控制炎症、缓解瘙痒,为皮肤屏障的修复创造条件,在医生指导下短期、规范使用是安全的。
- 如何选择: 医生会根据宝宝的年龄和湿疹严重程度,选择合适强度的激素药膏,如地奈德乳膏、丁酸氢化可的松乳膏等,通常从弱效或中效开始。
- 使用方法: “有效即停”,在红肿、渗出等急性期症状控制后,就可以停用,然后继续加强保湿,或者遵医嘱“间歇性使用”(比如每周用2-3天)。
非激素类药膏:
- 如果家长对激素有顾虑,或者湿疹面积不大、程度较轻,可以在医生指导下选择非激素类药膏作为一线或二线治疗。
- 常见的有他克莫司软膏、吡美莫司乳膏(适用于2岁以上),以及氧化锌软膏、医用敷料等,它们通常起效较慢,但长期安全性较高。
继发感染的治疗:
- 如果医生判断湿疹已经继发细菌感染(流黄水、化脓),可能会开口服或外用的抗生素药膏。
第三步:关于饮食(需谨慎,遵医嘱)
食物过敏确实是部分宝宝湿疹的诱因,但不要自行给宝宝忌口,以免导致营养不良。
- 母乳喂养: 母乳是宝宝最好的食物,除非有明确证据表明妈妈进食某种食物后宝宝湿疹加重,否则不建议妈妈盲目忌口,如果怀疑,可以在医生指导下进行“回避-激发”试验,比如先回避牛奶、鸡蛋、海鲜等常见过敏原2-4周,观察湿疹是否好转,然后再尝试重新引入。
- 配方奶喂养: 如果是纯配方奶喂养的宝宝,且怀疑牛奶蛋白过敏,医生可能会建议换成深度水解或氨基酸配方奶粉。切记:更换奶粉必须在医生诊断和指导下进行。
给您的行动清单:
- 立即行动: 换成无香料的婴儿沐浴露和医用保湿霜。
- 坚持执行: 每天洗澡后3分钟内,厚涂保湿霜,一天多次。
- 排查环境: 确保衣物纯棉宽松,环境凉爽,避免刺激物。
- 防止抓挠: 勤剪指甲,必要时戴手套。
- 何时就医:
- 家庭护理1-2周后毫无改善或加重。
- 宝宝痒得哭闹不止,严重影响生活。
- 皮肤出现渗水、流黄水等感染迹象。
- 怀疑食物过敏,需要调整饮食。
请记住,宝宝湿疹是一个慢性、反复的过程,需要家长极大的耐心,通过科学的护理和必要的医疗干预,绝大多数宝宝的湿疹都能得到很好的控制,随着宝宝年龄增长,皮肤屏障功能逐渐完善,湿疹也会慢慢好转,祝宝宝早日康复!
标签: 新生儿湿疹日常护理 新生儿湿疹用药注意事项 新生儿湿疹脸护理
版权声明:除非特别标注,否则均为本站原创文章,转载时请以链接形式注明文章出处。